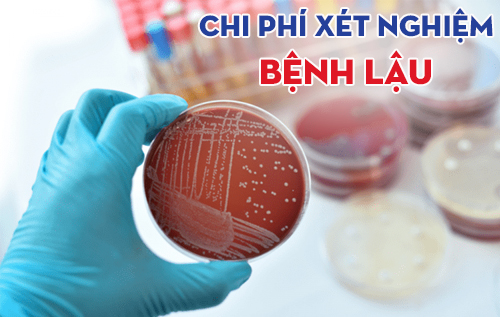

Việc tìm kiếm một địa chỉ khám chữa bệnh lậu uy tín là yếu tố giúp điều trị hiệu quả bệnh lý và ngăn ngừa các biến chứng. Một cơ sở y tế chất lượng không chỉ cần máy móc hiện đại mà còn phải đảm bảo sự riêng tư và bảo mật tuyệt đối cho khách hàng. Lựa chọn đúng nơi thăm khám sẽ giúp người bệnh tiết kiệm thời gian, chi phí và sớm quay lại cuộc sống bình thường.
Chỉ một cuộc trò chuyện ngắn với chuyên gia có thể giúp bạn biết rõ mình có mắc bệnh lậu hay không? (Nội dung trò chuyện được bảo mật và miễn phí)
Vì sao cần khám chữa bệnh lậu sớm?
Bệnh lậu là căn bệnh nhiễm khuẩn sinh dục, hậu môn, tiết niệu và họng do vi khuẩn Neisseria gonorrhoeae gây ra. Bệnh không chỉ gây lây truyền qua đường tình dục mà còn gây truyền qua các đường khác như đường máu, lây truyền từ mẹ sang con.
Đây là căn bệnh xã hội có tốc độ lây truyền nhanh chóng nên một khi người bệnh không phát hiện được tình trạng bệnh của mình sẽ khiến cho bệnh trở nặng và gây ra các biến chứng, có thể kể đến như:
Biến chứng của bệnh lậu đối với nam giới
– Nguy cơ cao mắc các bệnh xã hội khác như sùi mào gà, mụn rộp sinh dục, giang mai, HIV,…
– Mắc các bệnh nam khoa như viêm đường tiết niệu, viêm niệu đạo, hẹp niệu đạo, viêm tuyến tiền liệt,…
– Mắc các bệnh về tinh hoàn như viêm túi tinh, viêm tinh hoàn, teo tinh hoàn,… làm ảnh hưởng đến khả năng sinh sản, thậm chí là vô sinh.
– Nguy cơ cao mắc ung thư tinh hoàn.

Biến chứng của bệnh lậu đối với nữ giới
– Nguy cơ mắc các bệnh phụ khoa như viêm tử cung, viêm âm đạo, viêm buồng trứng, viêm vòi trứng,…
– Nguy cơ bị vô sinh hiếm muộn cao, sảy thai, mang thai ngoài tử cung, thai nhi bị dị tật,…
– Ảnh hưởng đến tâm lý và chất lượng cuộc sống.
KHUYẾN CÁO: Vì bệnh có thể gây ra các biến chứng cho sức khỏe nói chung và sức khỏe sinh sản nói riêng, do đó người bệnh nên hãy chủ động đi khám, xét nghiệm bệnh lậu để được bác sĩ kiểm tra, điều trị sớm khi có thể.
Nếu bạn đang gặp những biểu hiện bất thường nghi ngờ lậu, đừng tự chẩn đoán tại nhà! Hãy liên hệ ngay với chuyên gia để được tư vấn chi tiết về dấu hiệu bệnh và hướng xử lý kịp thời.
Một số tiêu chí giúp bạn tìm được địa chỉ khám chữa bệnh lậu uy tín
Ngoài việc tìm hiểu thông tin của bệnh lậu trước khi thăm khám thì người bệnh cũng nên tìm hiểu kỹ lưỡng một phòng khám, cơ sở chữa bệnh lậu để đảm bảo an toàn cho bản thân, tránh xảy ra trường hợp “tiền mất tật mang”.

Một số tiêu chí dưới đây có thể giúp bạn tìm ra được đâu là địa chỉ khám chữa bệnh lậu uy tín mà mình nên đến:
Cơ sở khám chữa bệnh phải có giấy phép hoạt động kinh doanh do Sở Y tế cấp phép.
Phải có đội ngũ nhân viên y tế giỏi, có trình độ chuyên môn cao, dày dặn kinh nghiệm, được đào tạo bài bản và phải có đầy đủ bằng cấp chứng minh được phép hoạt động thăm khám chữa bệnh rõ ràng.
Trang thiết bị máy móc y khoa hiện đại, tân tiến và phải được kiểm định chặt chẽ trước khi đưa vào hoạt động thăm khám chữa bệnh, nhằm đảm bảo an toàn cho người bệnh.
Chi phí thăm khám – điều trị phải được công khai, niêm yết giá rõ ràng minh bạch theo đúng quy định của Sở Y tế.
Một phòng khám uy tín chất lượng phải có chế độ bảo mật thông tin khách hàng cao, nhằm tránh trường hợp làm ảnh hưởng đến chất lượng đời sống, công việc của khách hàng.
GÓP Ý:
● Để đảm bảo an toàn và lựa chọn đúng cơ sở mà mình cần đến khi muốn điều trị bệnh lậu thì bạn cũng nên tham khảo và đọc qua các phần bình luận, đánh giá của những người bệnh đã từng thăm khám trước đó. Từ đó, có thể rút ra được một số kinh nghiệm cho bản thân và đánh giá được cơ sở, phòng khám đó có phải là nơi khám chữa bệnh uy tín mà mình nên đến hay không.
● Điều này, không chỉ giúp bạn tìm ra được địa chỉ khám chữa bệnh phù hợp với bản thân mà còn giúp cho quá trình thăm khám điều trị của mình được diễn ra an toàn, nhanh chóng, chính xác và hiệu quả. Hạn chế tối đa biến chứng xảy ra.
BẠN CÓ CÂU HỎI THẮC MẮC cần được tư vấn thêm? Đừng lo lắng, hãy cùng trò chuyện miễn phí với Bác sĩ chuyên khoa để được hỗ trợ giải đáp nhanh chóng.
Phòng khám chữa bệnh lậu hiệu quả, có bác sĩ giỏi tại Đồng Nai
Phòng Khám Đa Khoa Kiên Khang tự hào là địa chuyên khám và điều trị các bệnh xã hội lây truyền qua đường tình dục uy tín tại Đồng Nai, được đông đảo người bệnh tin tưởng, lựa chọn là nơi khám chữa bệnh an toàn cho bản thân.
Bên cạnh đó, còn là nơi hội tụ của nhiều bác sĩ chuyên khoa giỏi, có trình độ chuyên môn cao, giàu kinh nghiệm, được đào tạo bài bản tại các trường y có tiếng ở miền Nam và nước ngoài.
Cùng với đó là dàn hệ thống máy móc y khoa hiện đại, tân tiến được nhập khẩu trực tiếp từ các quốc gia có nền y học phát triển. Điều này, nhằm giúp cho quá trình thăm khám chữa bệnh của người bệnh được diễn ra an toàn, nhanh chóng, hiệu quả.
Chi phí điều trị luôn được công khai niêm yết rõ ràng, minh bạch theo đúng quy định của Sở Y tế nên bạn hoàn toàn có thể yên tâm khi điều trị bệnh lậu tại đây.
Hiện nay, Đa Khoa Kiên Khang Biên Hòa đang áp dụng công nghệ DHA tiên tiến vào trong quá trình điều trị bệnh lậu ở người bệnh. Phương pháp này giới chuyên gia đầu ngành đánh giá cao về mức độ hiệu quả khi sử dụng để điều trị cho người bệnh và cũng là phương pháp điều trị bệnh lậu phổ biến hiện nay.
Phương pháp DHA là phương pháp dùng điện trường làm sản sinh nhiệt lượng tại nơi biến chứng, chúng giúp cải tạo lại những đặc tính của tế bào, thu nhỏ và làm thay đổi tổ chức tế bào, giúp cho quá trình lưu thông của huyết quản thuật lợi hơn, làm thuyên giảm các triệu chứng viêm, phù và loại trừ mầm bệnh.

**Ưu điểm nổi bật của phương pháp DHA:
Thời gian điều trị nhanh chóng, không cần nằm viện.
Tính an toàn cao, không gây tác dụng phụ.
Tiêu diệt vi khuẩn một cách nhanh chóng, tăng khả năng miễn dịch cho cơ thể.
Tiết kiệm chi phí.
Hạn chế tối đa tái phát trở lại.
Trên đây là bài viết về thông tin bệnh lậu cũng như giải đáp câu hỏi đâu là địa chỉ chữa bệnh lậu uy tín ở Đồng Nai. Nếu bạn còn thắc mắc gì về bệnh lậu hay bất kỳ vấn đề gì, hãy liên hệ với chúng tôi theo Hotline: 0708 689 989 hoặc CLICK VÀO KHUNG CHAT để được chuyên gia tư vấn.